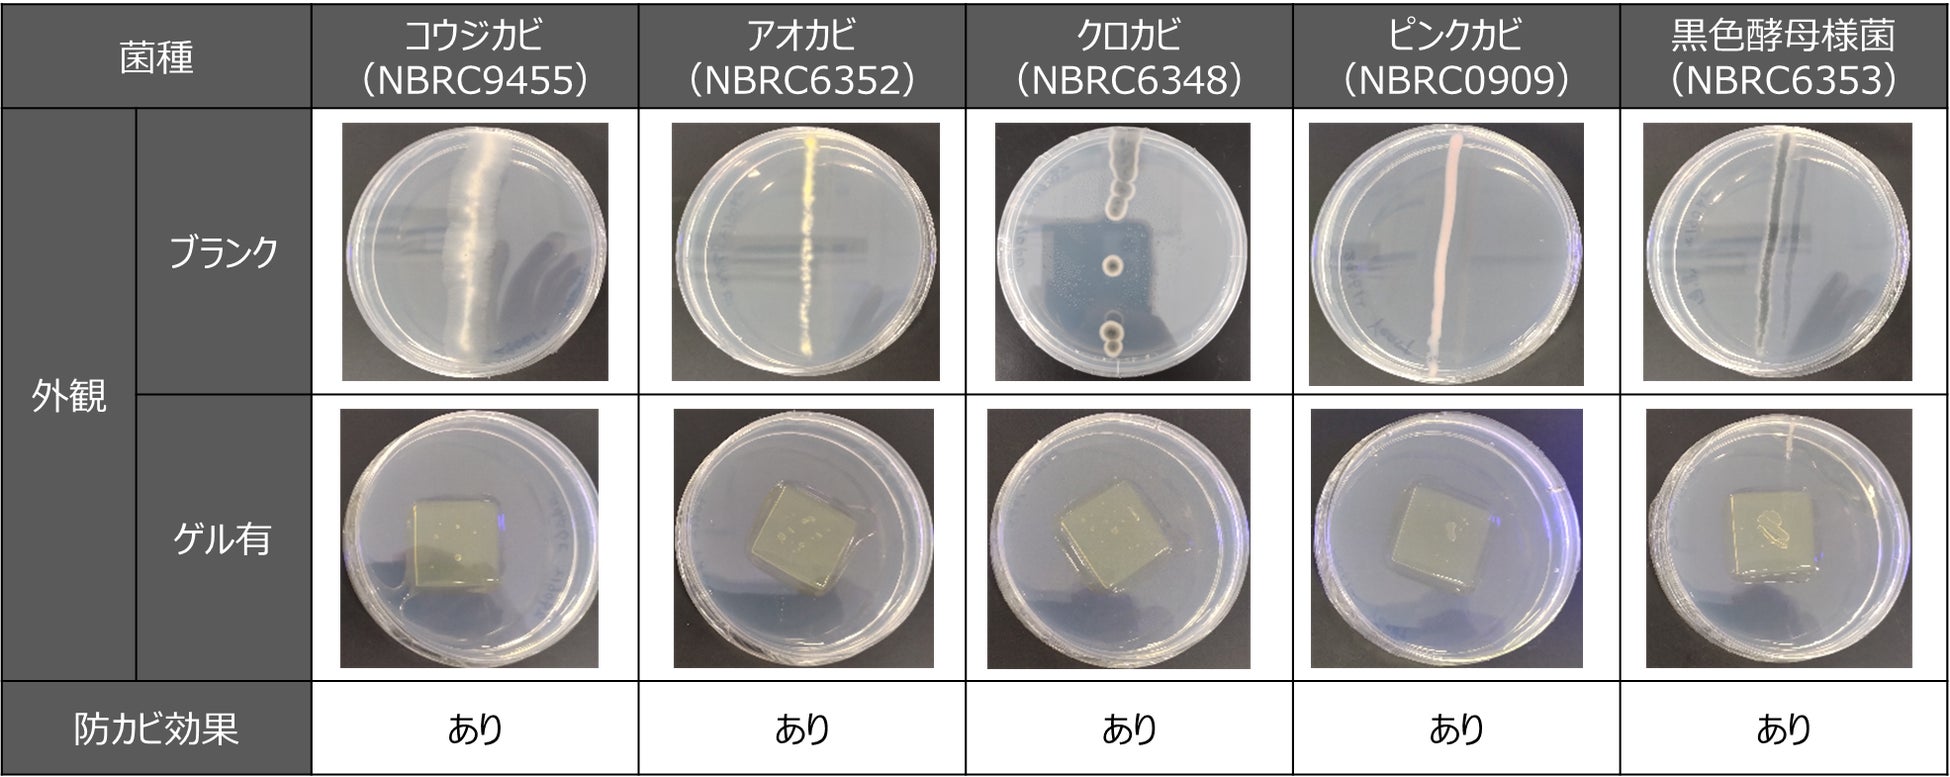

初のコラボレーション!ユシロ化学×日本製紙パピリア、防カビ成分を一切含まないにも関わらず、光で防カビ可能なゲルを共同開発
光防カビゲルを活用した製品開発にご協力いただける企業様に、500個限定でサンプルを無償配布
「光防カビゲル」は、ユシロ化学独自の〝光防カビ技術〟を、日本製紙パピリアの〝充填成型技術〟によりゲル状に成型したもので、独特の臭気や人体に影響のある従来の防カビ成分が⼀切含まれておりません。私たちは、この「光防カビゲル」で従来の技術では対応が困難であったカビに関するさまざまな課題の解決を目指しております。
製品化の実現に向け「光防カビゲル」を活用した製品開発にご協力いただける企業様に、500個限定で無償サンプルを配布いたします。あらゆる業種・業態からの幅広いご応募をお待ちしております。お気軽にご連絡ください。

光防カビゲルの概要
「光防カビゲル」は「従来の防カビ剤が持つ独特な臭気」や「発がん性物質が混入するリスク」といった懸念から、製品の防カビ対策に苦慮されている企業様の商品開発の鍵になり得ます。
【特徴】
・防カビ成分非含有
従来の人体に影響のある防カビ成分が一切含まれておらず、光を当てることにより光触媒作用で
防カビ効果がゲル周囲に及びます。
図1 光防カビゲル
・無臭
「光防カビゲル」は無臭です。(従来の防カビ成分の中には独特な臭気を持つものがあります。)
・長期間の持続
光の強さに比例して防カビ可能な空間体積(有効体積)が広がります。また、防カビ効果の持続性も
向上します。
※ 光の照射条件により3か月以上の持続効果が期待できます。
メカニズム
「光防カビゲル」はユシロ化学独自の光触媒技術であるジェンタミン®※を活用し、光によってラクトアルデヒドを防カビ成分として少量ずつ放出する仕組みとなっています。ラクトアルデヒドは無臭であることに加えて、空気中の酸素による酸化や代謝を受けて安全性の高い乳酸に変化します。
※ジェンタミン®:海藻、牛乳、アーモンド等に含まれるビタミンB2を活用した安全性の高い光触媒添加剤
【コア技術】
アルデヒドの多くは酸素による酸化や縮合反応が起こりやすく、化学的に不安定であるため製品に添加することが困難とされています。私どもユシロ化学はジェンタミン®を活用することで、アルデヒドを一切配合せずにさまざまなアルデヒドを光で少量ずつ放出することを可能としました。
エビデンス(気相防カビ試験)
【試験方法】
培地を注入した深型滅菌シャーレに白金耳を用いて各カビの混濁液を画線塗布しました。逆さにしたシャーレに光防カビゲルを封入し、図2に示すようにセットしました。明条件(白色LED:1,500lx)、25℃の条件下で3日間培養し、培地上の菌糸を目視で観察しました。
図2 気相防カビ試験の試験方法
【試験結果】
光防カビゲルを封入したサンプルについて、カビの増殖抑制効果が認められ、本防カビゲルの光防カビ効果を確認しました。
※試験結果は参考値であり、効果を保証するものではありません。
会社概要
会社名:ユシロ化学工業株式会社
代表者:有坂 昌規
所在地:東京都大田区千鳥2-34-16
設立年:昭和19年7月24日
資本金:4,249百万円
事業内容:金属加工油剤(切削油剤、圧延油剤、引抜油剤、プレス油剤、ダイカスト離型剤、さび止め油剤、洗浄剤等)、ビルメンテナンス製品(フロアメンテナンス用ワックスおよび剥離剤、洗浄剤、メンテナンス用機器)の製造・販売
会社名:日本製紙パピリア株式会社
代表者:西口 恭彦
所在地:東京都千代田区神田駿河台4丁目6番地
設立年:大正7年7月25日
資本金:3,949百万円
事業内容:特殊紙・紙加工製品・化粧品関連製品の製造・販売
*主題の通り、ユシロ化学と日本製紙パピリアのコラボレーションは初の試みです。
このプレスリリースには、メディア関係者向けの情報があります
メディアユーザー登録を行うと、企業担当者の連絡先や、イベント・記者会見の情報など様々な特記情報を閲覧できます。※内容はプレスリリースにより異なります。
すべての画像
